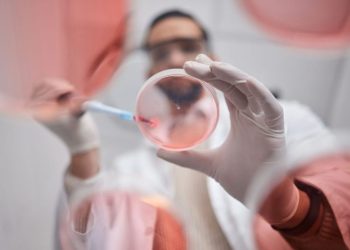
Pharma Market Forecast: Top Trends for Pharma in 2025

Bitcoin Slips to $83.6K Amid Nvidia’s $5.5B Charge
October 7, 2025
Uranium Price Update: Q3 2025 in Review
October 16, 2025
Top 10 Potash Countries by Production (Updated 2024)
August 21, 2024
Top 10 Phosphate Countries by Production (Updated 2024)
August 1, 2024